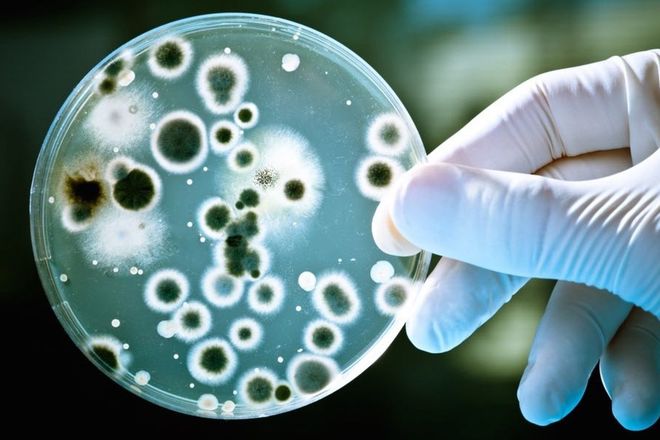

Кредитные билеты вполне могут переносить коронавирус. Как с этим борются.
С самого начала эпопеи с распространением коронавируса, стал подниматься вопрос о том, может ли зараза переноситься через деньги. Выяснилось, что - может.
Нацбанк решил отправлять поступающую от банков наличность на две недели в карантин из-за распространения в мире коронавируса, - заявил глава НБУ Яков Смолий. По его словам, гривневая наличность, которая поступает в центральное хранилище Нацбанка, будет храниться там две недели - ровно столько длится инкубационный период коронавируса. Такую меру примут из-за опасности заражения сотрудников банка.
По словам главы НБУ, процесс обработки наличности в центральном хранилище - это технологический цикл, где пересчитывается вся наличность, утилизируется непригодная часть, а остальная - возвращается в оборот.
Директор Центрального хранилища Национального банка Виталий Брик рассказал о технических моментах обработку купюр: "Пригодная наличность будет упакована в термоусадочную пленку. Этот процесс упаковки предусматривает прохождение пачки банкнот через термотоннель, где поддерживается температура минимум 160 градусов. Это уже дополнительный шок для вирусов”.
Пресс-служба НБУ обнародовала видео, на котором продемонстрирован весь процесс обработки банкнот от коронавируса.
В то же время, заместитель главы НБУ Екатерина Рожкова рекомендует украинцам ограничить контакт с наличными деньгами в связи с пандемией коронавируса.
"Мы должны помнить, что самым безопасным является безналичный способ оплаты", - заявила Екатерина Рожкова.
Чужой опыт
Посетили аграрного рынка в городе Поти обязаны на входе отдать имеющиеся деньги специальному сотруднику для дезинфекции, - передает Первый канал Грузии.
Дезинфицируют деньги при помощи... утюга, который обеззараживает купюры. А для монет применяют обычный антисептик.
Также посетителям выдают на входе перчатки и меряют температуру. Директор рынка Нодара Корсанти заявил, что работники дают сдачу только дезинфицированными деньгами.